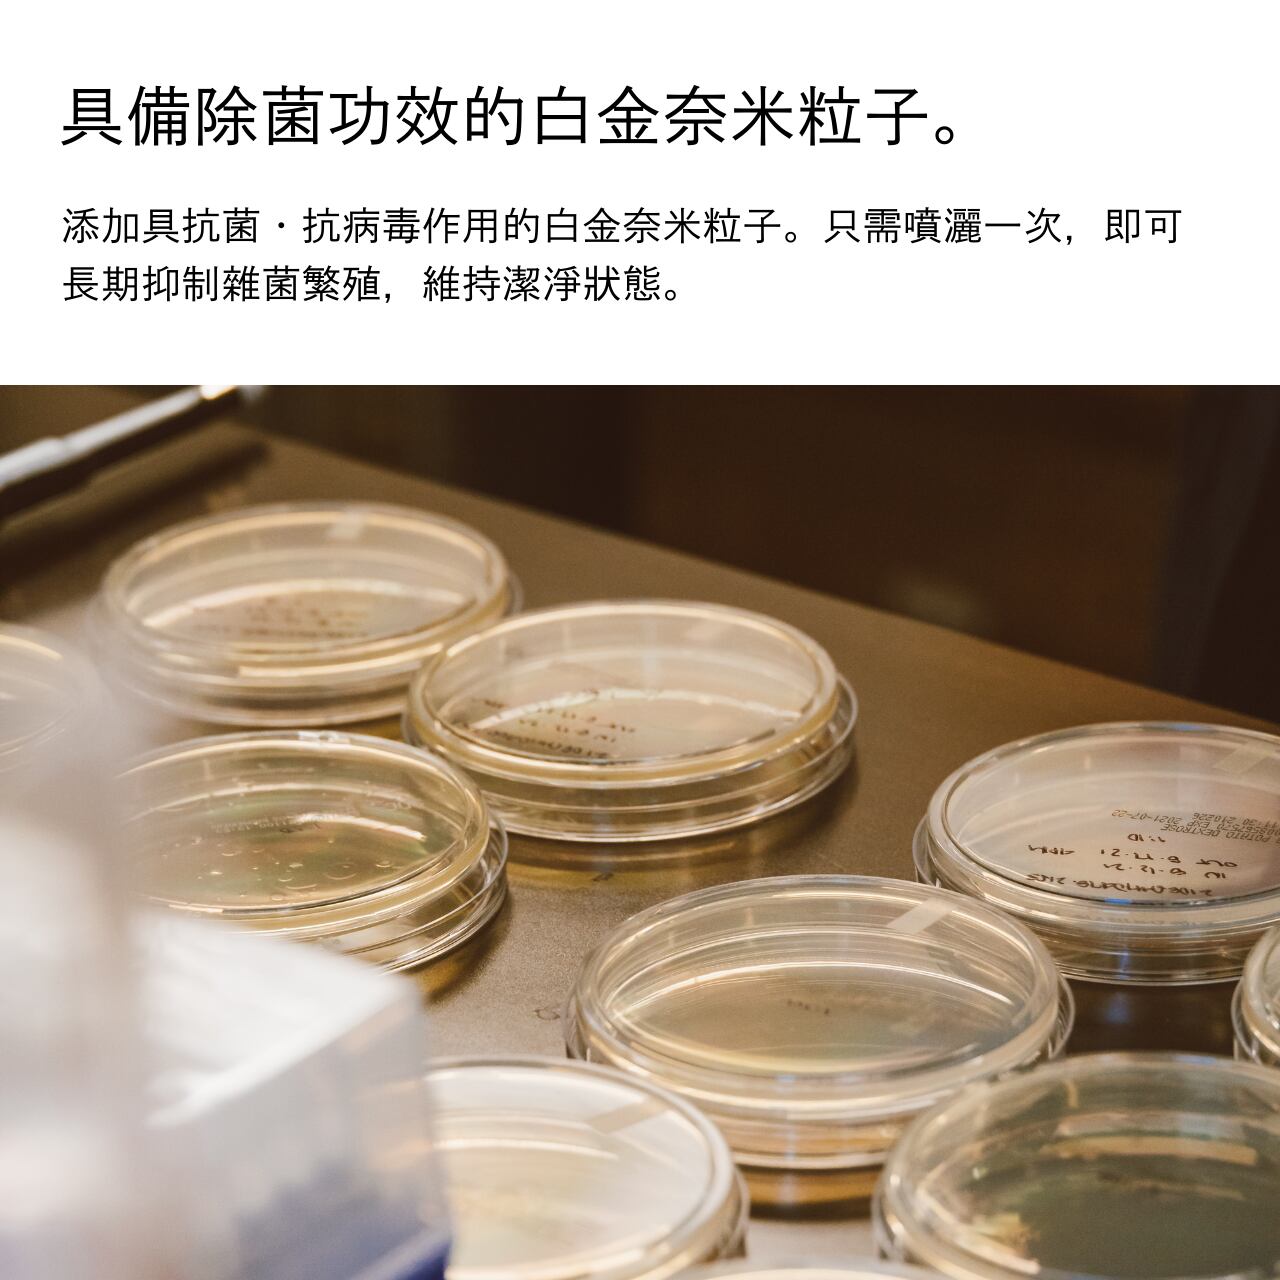

【原創地圖特典】Aromatic Fabric Mist 3入組〈數量限定〉
¥5,500 税込
なら 手数料無料で 月々¥1,830から
別途送料がかかります。送料を確認する
この商品は海外配送できる商品です。
附著在衣物上的油炸食物氣味,或是出差時住宿飯店的氣味。
只需在衣物、寢具或空間中輕輕一噴,這款織物噴霧便能重置惱人異味,讓舒適香氣輕柔瀰漫開來。
隨時隨地都能使用的便利尺寸,輕鬆放進口袋。
特別推薦作為喜愛外食或喜歡旅行的人的贈禮。
POINT
・天然消臭成分「柿單寧」能消除附著於衣物上的料理氣味與體臭,讓異味不復存在
・具抗菌・抗病毒效果的「白金奈米粒子」能長期抑制雜菌繁殖
・僅以精油調製的自然舒適香氣
・不僅適用於衣物、寢具等布製品,亦可作為空間香氛使用
・容器採用美觀且高級感的霧面玻璃瓶
・乙醇濃度低於24%,因此可寄送至日本境外
[香氣特徵]
■TOKYO
清新薄荷與木蘭花、芫荽的甘甜交織出和諧氣息,令人聯想雞尾酒「Grasshopper」。給人清爽而精緻的印象。
■OSAKA
以苦橙與葡萄柚的苦澀柑橘香調為基底,融合木質香氣,呈現無甜味的清爽氣息。香氣能在短時間內自然消散,因此無論何種場合皆能自在使用。
■FUKUOKA
以藍艾菊、天竺葵與米仔蘭為基調的綠色花香調。花香與橡苔、佛手柑和諧交融,散發如海風般清新潤澤的氣息。
[使用方法]
充分搖勻後,距離衣物、寢具等布料約20~30公分噴灑
成分:水、乙醇(24%以下)、界面活性劑、除臭成分、除菌成分、香料
內容量:20mL×3瓶
原產國:日本
※關於付款方式※
本線上商店因採用日本電子商務購物車系統,故無法使用海外發行的信用卡進行付款。海外購買時,可使用Amazon Pay、PayPal、銀行轉帳等付款方式。
-
送料・配送方法について
-
お支払い方法について
[購入者特典について]
購入者全員に、オリジナルマップをプレゼント!
ガイドブックや口コミサイトには載っていない“いいお宿”と“いいお店”だけを厳選しました。
旅行に、お出かけに、デートに。
どんな時も頼りになる、特別なマップです。